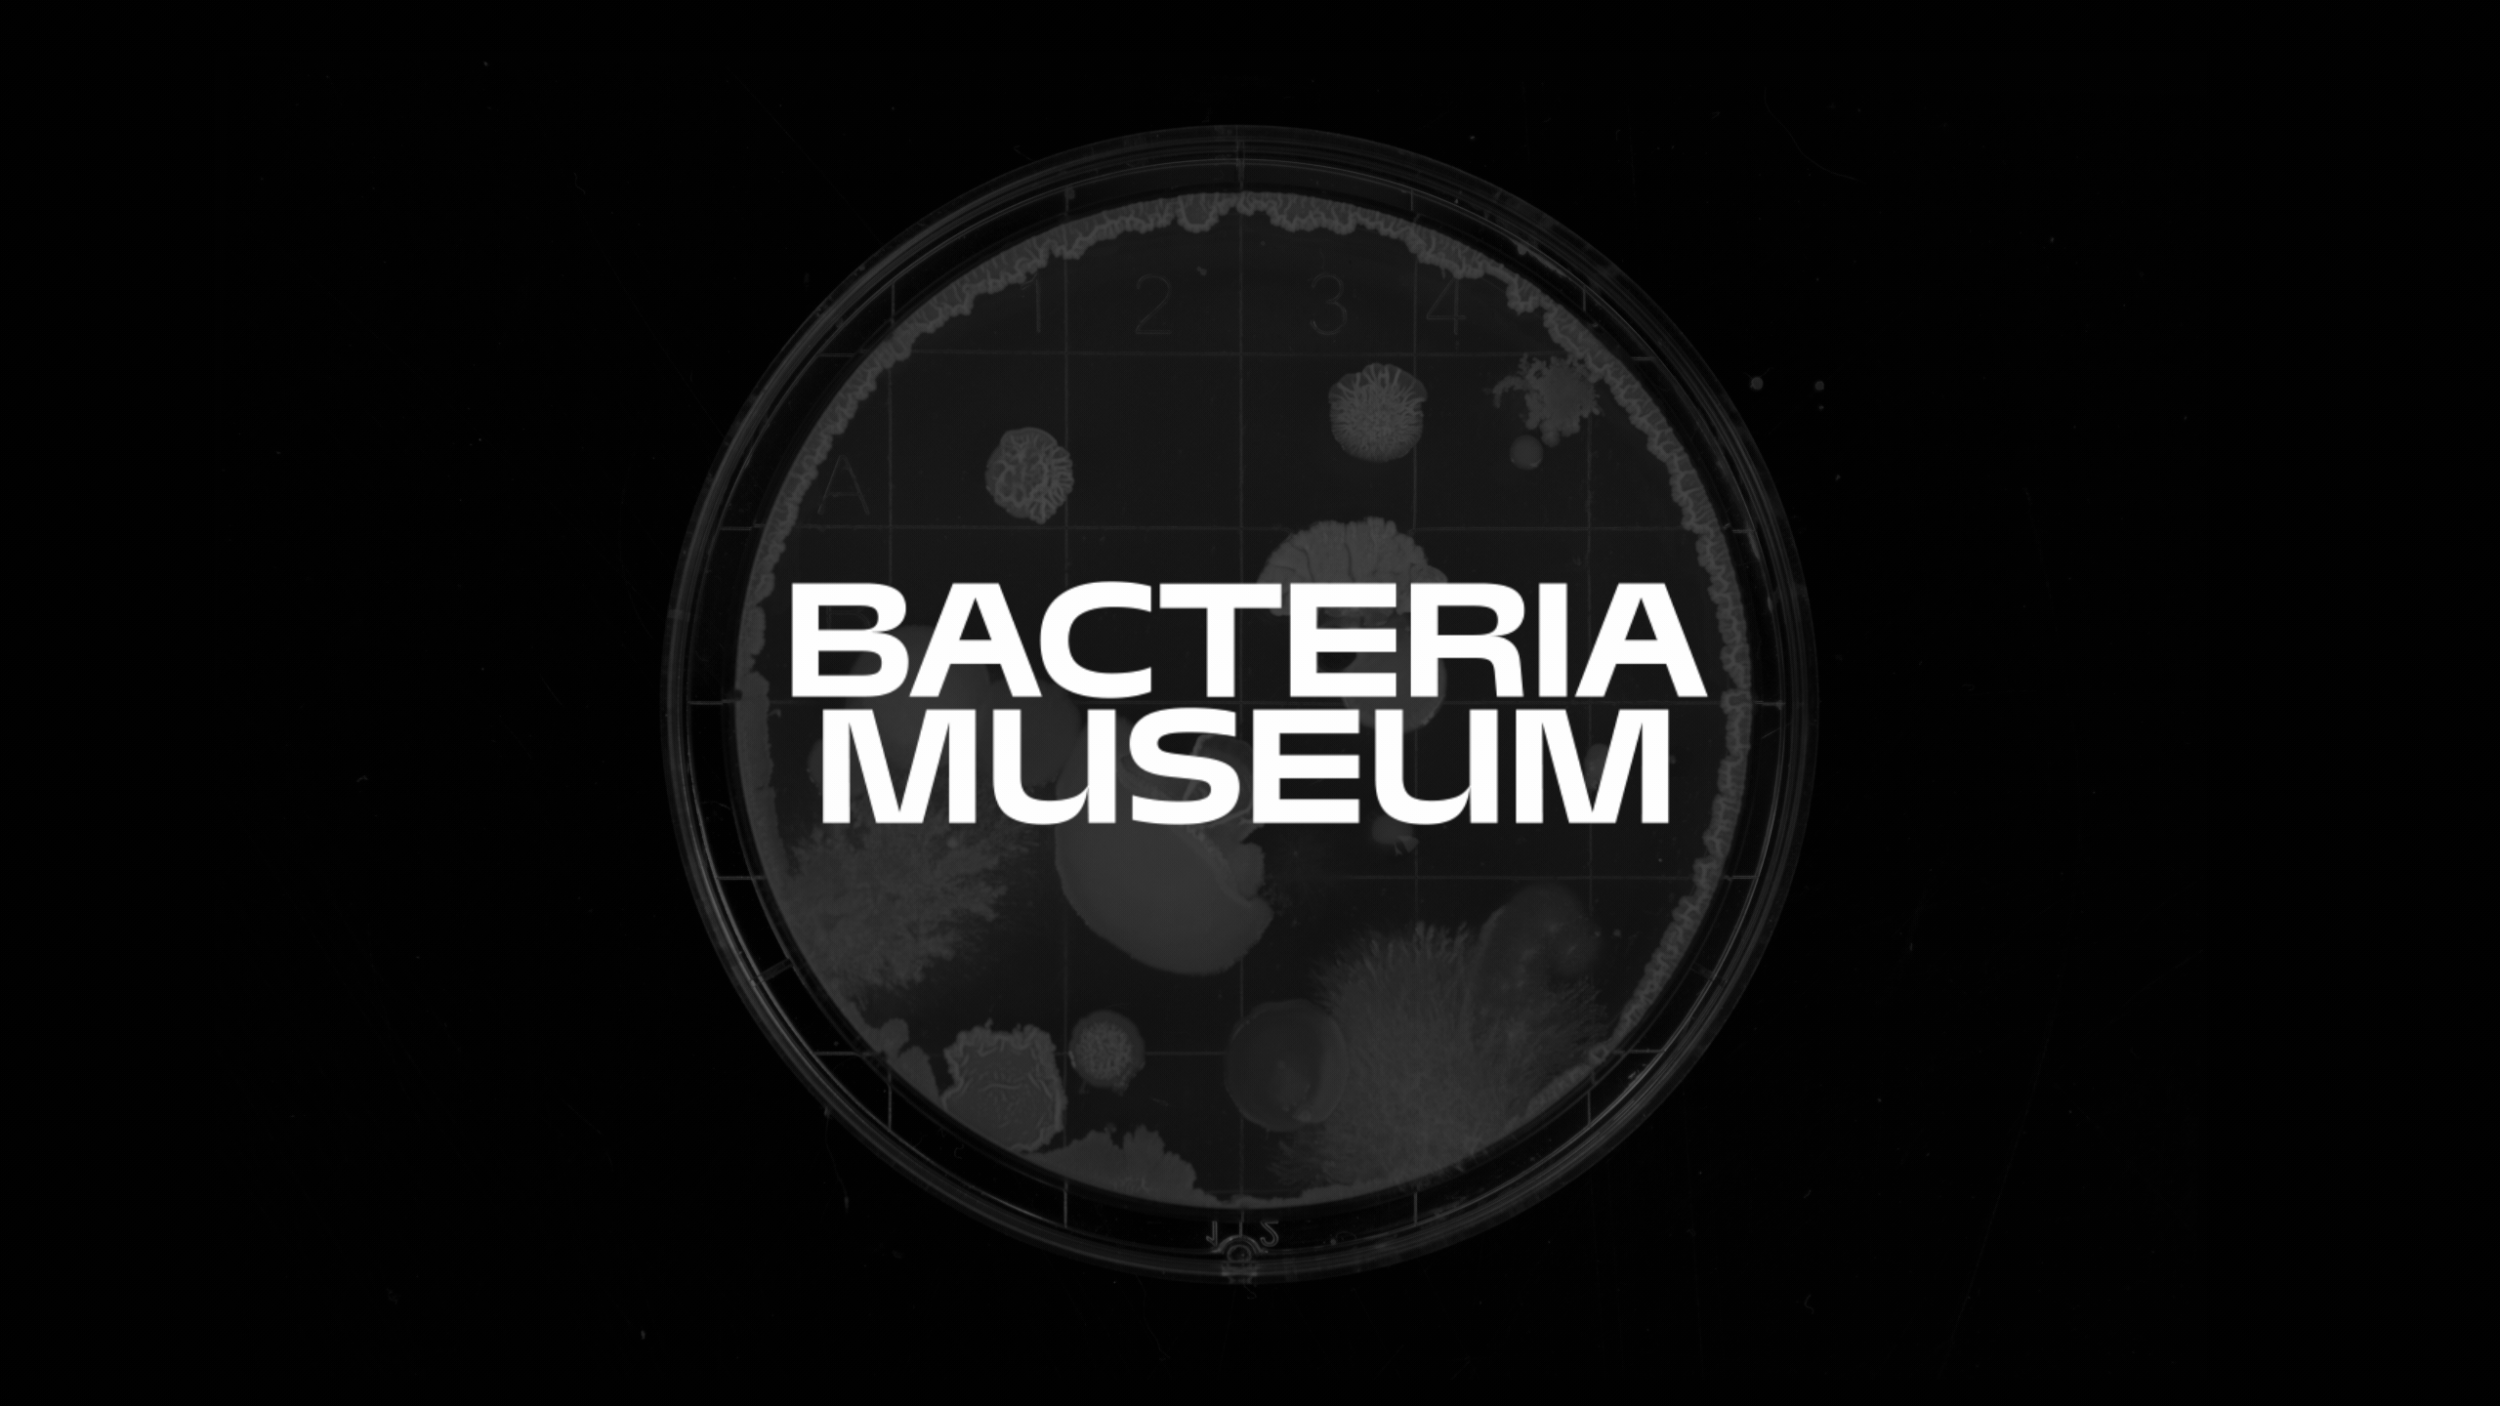

A multidisciplinary designer with a
focus on motion and brand design,
based in New York & Shenzhen.
Motion/Identity
Abridge
Motion/Identity
General Catalyst
Motion/Identity
Procreate Dreams: Circles
Motion/Illustration
MOYNAT CNY '25 Shorts
Motion/Illustration
Motion/Identity
Pfizer

(Available Upon Request)
Jayson Tatum X Jordan
Campaign/Art Direction
Motion/Illustration
Instant Evolution
Mütter Museum
Identity/Type Design
Kong Sihk Tong 港食堂
Identity/Type Design
Tongues of China 中国话
Motion/Illustration
Identity/Type Design
Bacteria Museum